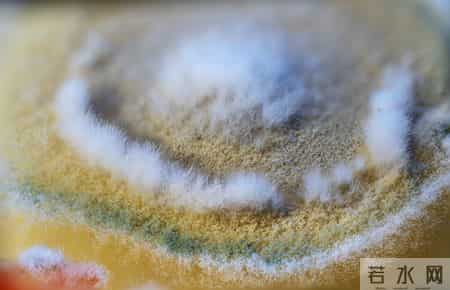
冰箱里的3个东西，是白血病的致病原因之一，要尽早丢掉！

冰箱里的3个东西,是白血病的致病原因之一,要尽早丢掉!

“妈,你又把前天剩的饭留冰箱里啦?”晚上,52岁的王阿姨从冰箱里拿出一碗泛着绿色斑点的米饭,正准备热一热给家里人吃。“别浪费嘛,冰箱就是用来保鲜的!”她笑着说。
可在另一边,王阿姨邻居刘大叔,去年身体突然不适,最终被诊断为白血病,医生一再追问饮食和生活习惯,才发现家里冰箱常年塞着发霉的食物。
当然,白血病并不是某一种食物引起的,但一些“隐形杀手”很可能正潜伏在你家的冰箱里。

冰箱,曾经是家庭饮食健康的代名词。但你不知道的是,不当保存的食物,可能悄悄威胁你的健康,甚至被证实与癌症风险有关。尤其是其中3类常见东西,被权威医学研究多次提醒——务必尽早处理,否则等到身体出问题时再后悔就晚了。
那么,冰箱里的“健康雷区”到底指的是什么?哪些细节容易被忽视?最危险的第一个,你可能每天都在接触。本文将详细解读,帮你守护家人安全。
冰箱里的“健康陷阱”:不是保鲜,而是埋下健康隐患?很多人以为冰箱就是储存安全食物的万能法宝。但科学研究提醒,冰箱并不能杀灭病菌,只是延缓细菌、霉菌繁殖速度。
有研究显示,大部分家庭冰箱的温度其实并不稳定,波动范围在4℃~10℃之间,而部分有害微生物低温下仍能缓慢生长繁殖。尤其是以下三种东西,如果长期储存在冰箱里,微生物、毒素堆积更危险。

发霉变质的剩饭剩菜
许多家庭有“勤俭节约”的习惯,隔夜饭菜放进冰箱以为万无一失。可事实上,剩饭菜易滋生黄曲霉素,它是一类强致癌物。研究发现,长时间存放的剩饭剩菜即便冷藏,“肉眼看不到霉变”并不等于安全。
实际检测发现,放置超过48小时的剩饭菜中,有害物质检出率提升达36%。世界卫生组织已把黄曲霉素列为Ⅰ类致癌物,和白血病、肝癌等多种癌症风险相关。
存放过久的水果、蔬菜
不少人买菜喜欢一次性囤一周,水果蔬菜在冰箱一放就是好多天。殊不知,果蔬若局部出现霉点、腐烂后,即使切掉表层,内部也可能渗入了看不见的霉菌毒素。
学者指出,水果只要出现霉点,60%以上的样本内部都检出了黄曲霉素或赭曲霉素。尤其是冷藏条件不佳、袋装捆绑的生鲜,反倒更容易产生毒素累积。
红色预警:发霉的面包与坚果
有经验的主妇都见过,冰箱里偶尔遗忘的一袋面包,打开后闻起来“怪怪的”。面包、坚果等富含油脂和糖分的食物,极易感染曲霉菌,形成极强致癌性的毒素,比如黄曲霉素B1。
有权威数据指出,每周食用发霉坚果、面包的人群白血病患病率提高了约20%。更危险的是,这些食物往往被认为“冷藏没事”,但毒素依然潜在,难以完全清除。
 健康恶果:无声的“慢刀”,你以为不痛不痒,其实伤害悄然发生
健康恶果:无声的“慢刀”,你以为不痛不痒,其实伤害悄然发生
许多白血病患者回忆,发病前并无异常症状;而多数家庭,冰箱食品却普遍存在“不舍得扔”、“回锅加热就能吃”的观念。殊不知,这些看似不起眼的“小习惯”,正是健康的隐形杀手:
反复进出冰箱,温差波动让食物短时间内进出菌落繁殖高峰;霉变黄曲霉素摄入后,部分人群肝脏难以有效分解,长期微量暴露会影响骨髓造血系统,增加白血病等疾病风险;

有研究表明,不仅肝癌、消化道肿瘤,黄曲霉素毒素与白血病的相关性得到越来越多证实,慢性摄入可导致造血系统基因突变;免疫力本就偏弱的中老年人、儿童,一旦不慎摄入积蓄的霉菌毒素,相比成年人更容易引起造血功能异常甚至更严重后果。
隔夜饭菜回锅加热虽能杀灭部分细菌,却去不掉已经产生的毒素。一份临床观察发现,反复食用发霉食物的人群,白血病风险较正常饮食者高出近14.8%。
守护家人健康,每个人都能做到!医生5条实用建议,今天就能开始有效预防来自生活细节的把控。专家建议,从下面5个方面做起:
立刻丢掉任何可见霉变、变味、颜色发暗的食物,勿侥幸“切掉表皮就能吃”;剩饭剩菜冷藏不超过24小时,食用前务必彻底加热;建议现做现吃;水果蔬菜买少量、多次,避免长时间囤积;若发现变软、变色、出水应果断丢掉。

定期(每周)清理冰箱,保持冷藏温度在4℃以下,冷冻区在-18℃以下;家有老人、孩子,尤其要注意坚果、面包等高风险食物,建议小包装、快食用,发现异常立即处理。
本文为健康知识科普,结合权威资料和个人观点撰写,部分情节为方便表达和阅读理解进行了适当虚构与润色,内容仅供参考,不能替代医生诊断。如感不适,请及时就医。收藏以备不时之需,转发给你关心的人!
参考资料:
《黄曲霉素B1与食品安全风险研究综述》
《白血病病因与防控指南(2021)》
《中华医学会血液学分会:白血病流行病学报告》
《冰箱储存食物的微生物风险分析》
相关信息
- 冰箱里的3个东西,是白血病的致病原因之一,要尽早丢掉!
- 65岁大爷血压骤降昏迷,医生:苯磺酸氨氯地平不可和这5种药搭配
- 多位医生警示:天冷长期戴口罩,半年内七种不适悄然逼近
- 我亲姐得了肠癌晚期有肝转移,医生说也就是两个月的事了
- 什么样的糖化血红蛋白最危险?专家:这5种异常,你了解吗
- 体检报告里这5项异常,竟是心梗信号?9成人不重视,后悔太晚!
- 得了冠心病,忌口是铁律!医生:这7类食物要限制,避免加重病情
- 血脂达标不用吃阿托伐他汀?专家研究:高危人吃了有助于防心梗
- 老人“黄金心率”已公布!不是65次,而是这个数,越接近越健康
- 人过六十,宁可每天闲在家里,也别去碰这4件事,守住余生安稳
- 研究发现:能长寿的糖尿病患者,在确诊后,就慢慢远离这9事了
- 提醒:5种粗粮越吃越伤身,很多人把它们当成宝,或许你们吃错了
- 医生:糖尿病加重的 6个危险信号!出现 1 个就该重视,千万别拖
- 癌症患者化疗必须做满6个疗程?肿瘤科医生告诉你真相!
- 瘦了20斤,懂了:晚上蛋白质一定要吃够!掉秤真快!
- 确诊高血压的人越来越多?医生多次嘱咐:饭后1种习惯要少做!
- 23岁男子信偏方把5cm水蛭塞进尿道,致剧烈疼痛、排尿困难,医生提醒
- 又出血液肿瘤新药!百济神州股价微跌,“创新药一哥”能再造爆款?
- 老年人要戒烟吗?医生告诫。60岁以后的老人,吸烟牢记4不吸
- 医生提醒:早上起床后有这6个表现,恭喜你,说明你的身体还不错